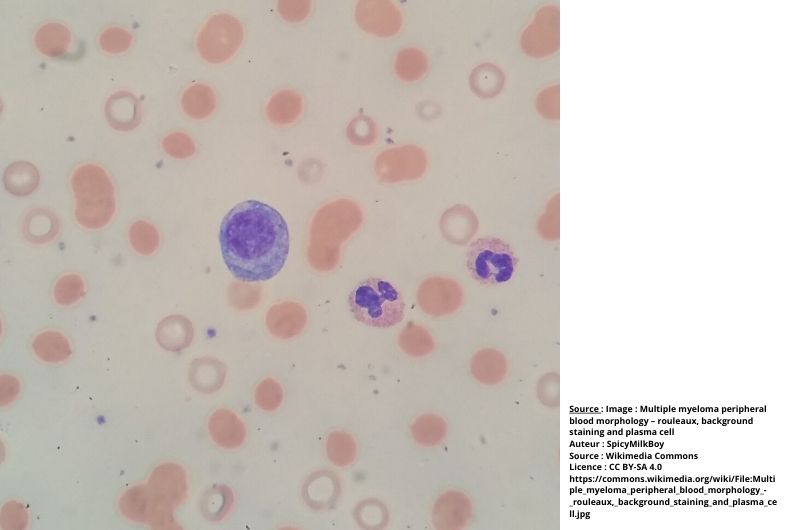
fichier-programme-quelles-taches-agricoles-sont-a-risque-de-myelome-multiple-12122025100356.jpg

Les résultats
AGRICAN

Quelles expositions sont liées au risque de cancer de l’ovaire dans AGRICAN ?
Le croisement des données de la cohorte avec les registres de cancer a permis d’identifier 262 cas de cancer de l’ovaire. L’incidence de ce cancer ne semble pas différente entre les femmes d’AGRICAN et celles de la population générale. En revanche, les analyses conduites sur les caractéristiques professionnelles des femmes d’AGRICAN révèlent des excès de risques associés à certaines expositions agricoles spécifiques.
AGRICAN

Les espaces verts : un secteur peu documenté et pourtant concerné par les expositions professionnelles aux pesticides.
Plus de 6000 travailleurs en espaces verts participent à la cohorte AGRICAN. Le croisement des données avec les registres de cancers a permis de mettre en évidence des excès de risque par rapport aux agriculteurs pour certaines localisations de cancer.
AGRICAN

Quelles activités agricoles sont liées au risque de cancer colorectal dans AGRICAN ?
Nous avons identifié 2 609 cas de cancer colorectal dans la cohorte entre l’inclusion et le 31 décembre 2017. Certains élevages et cultures étaient particulièrement associés au cancer colorectal. Ce cancer touche différemment les hommes et les femmes, nous les avons donc étudiés séparément.
AGRICAN

Quelles activités agricoles sont liées au risque de sarcome ?
Dans notre population, 188 cas de sarcomes incidents ont été identifiés. Les premières analyses montrent que le risque de sarcome était accru pour plusieurs activités agricoles, avec des différences selon le sous-type histologique étudié.
AGRICAN

Les réponses du questionnaire d’inclusion sont-elles fiables ?
739 personnes ont répondu 2 fois par inadvertance au questionnaire d’inclusion dans la cohorte AGRICAN. Leurs réponses étaient dans l’ensemble très similaires. Ce constat renforce la qualité de nos résultats sur le lien entre expositions agricoles et santé.
AGRICAN

Projet DEPARE : un projet pour étudier les troubles de la reproduction et du développement de l’enfant
En 2016, ce projet a été mis en place auprès de 1 150 femmes ayant eu une grossesse depuis 2005. Les premières analyses ont porté sur le délai nécessaire à concevoir.
AGRICAN
Quelles tâches agricoles sont à risque de myélome multiple ?
Les expositions aux pesticides dans le secteur des cultures mais aussi aux insecticides et aux désinfectants en élevage étaient associées au risque de myélome multiple.
AGRICAN

La survenue de la maladie de Parkinson est-elle plus fréquente dans certains secteurs agricoles ?
A l'inclusion, 1 732 personnes ont déclaré souffrir de cette maladie. Tous les élevages et presque toutes les cultures étaient associés à un risque accru, notamment en lien avec l’utilisation de pesticides. Des élévations de risque étaient observées en lien avec l’exposition à certains fongicides dithiocarbamates.
AGRICAN

Quels sont les premiers résultats concernant les cancers du cerveau ?
Les premières analyses indiquent que l'exposition globale aux pesticides est associée au risque de tumeurs cérébrales, avec des risques particulièrement élevés pour certains pesticides de la famille des carbamates.
AGRICAN

L’incidence de cancers est-elle plus élevée dans la cohorte qu’en population générale ?
Nous avons comparé l'incidence de 43 cancers entre la population agricole (cohorte AGRICAN) et la population générale. Certains cancers ont été retrouvés en excès dans AGRICAN (prostate, cancers hématologiques, lèvre, mélanome cutané).
AGRICAN

Quelles sont les expositions agricoles associées au risque de cancer pulmonaire ?
Environ 900 participants ont développé un cancer pulmonaire entre l'inclusion et le 31/12/2011. Certaines expositions en élevage étaient associées à des diminutions de risque, tandis que d'autres, dans le secteur des cultures, étaient associées à des élévations de risque.
AGRICAN

Qui sont les agriculteurs à risque de cancers de la vessie ?
Après un suivi de 5 ans, environ 180 personnes ont développé un cancer de la vessie. Des élévations de risque ont été observées pour les secteurs suivants : cultures sous serres, maraîchage, pois fourragers/féveroles et colza.
AGRICAN

Quels sont les élevages et cultures associés au risque de cancer de la prostate ?
Les analyses conduites suggèrent un risque de cancer de la prostate plus élevé dans plusieurs activités agricoles, notamment l'élevage de bovins et de porcs, le travail dans les prairies ou l'arboriculture. Certaines tâches impliquant l'utilisation de pesticides apparaissent également associées.
AGRICAN

Quels sont les secteurs agricoles associés au risque d'asthme ?
Dans un échantillon des répondants de la cohorte, 8% étaient asthmatiques. Les premières analyses ont permis d'identifier les secteurs agricoles à risque d'asthme allergique et non allergique.
AGRICAN

Quels secteurs agricoles sont à risque de bronchite chronique ?
Les premières analyses sur un échantillon de la cohorte révèlent une prévalence de 8,4% de bronchite chronique. L’élevage de bovins et la culture de pomme de terre étaient des secteurs à risque pour cette maladie respiratoire.
